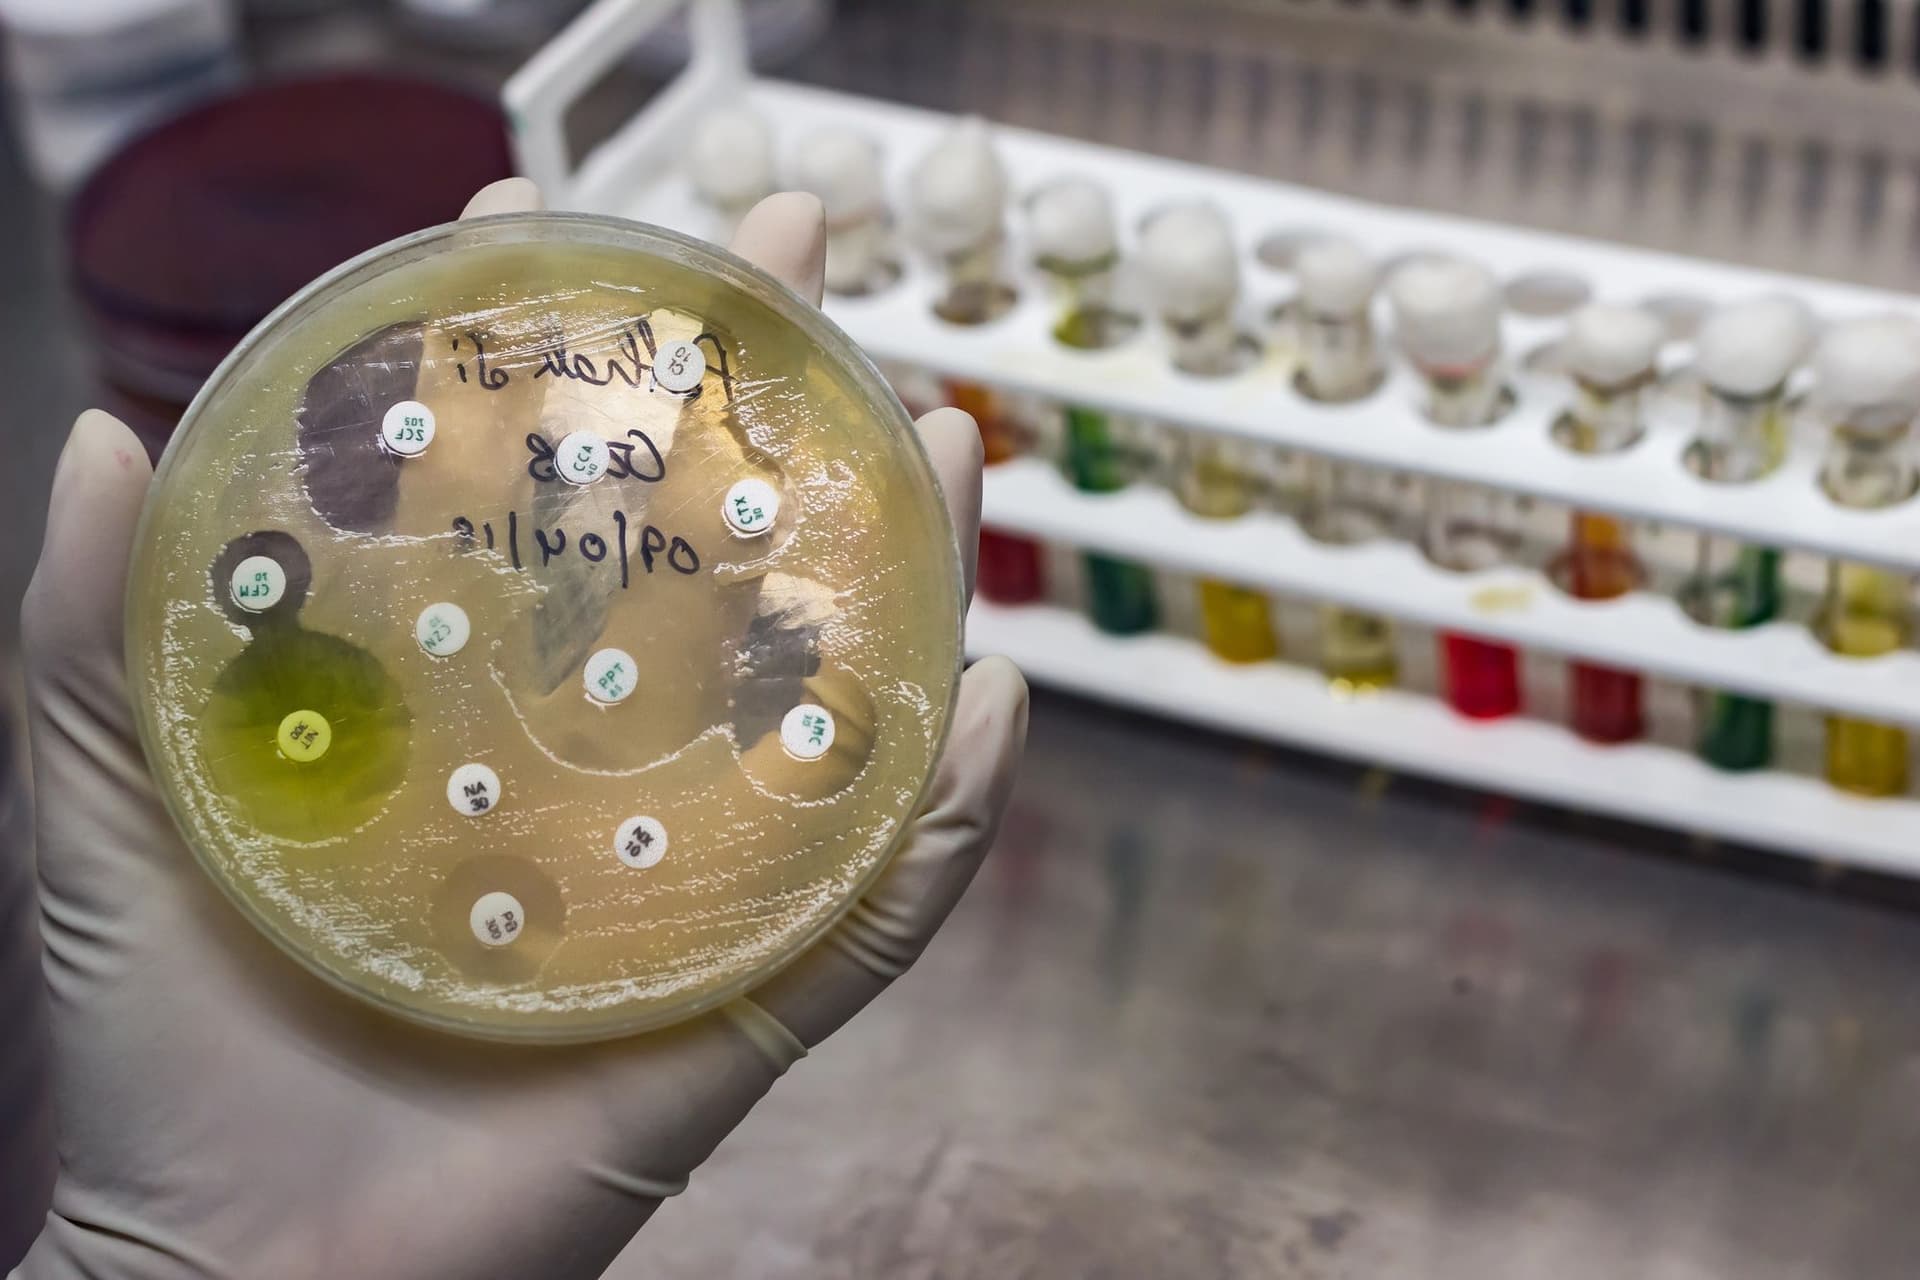
Article image

Резистентність до антибіотиків може спричинити майже 40 млн смертей до 2050 року
Новий глобальний аналіз прогнозує, що до 2050 року стійкість бактерій до антимікробних препаратів може стати причиною понад 39 мільйонів смертей, причому особливо вразливою групою є люди похилого віку.
Хоча смертність серед маленьких дітей зменшується завдяки покращенню вакцинації та гігієни, дослідження виявило протилежну тенденцію серед людей старшого віку. Очікується, що до середини століття 1,91 мільйона людей щорічно помиратимуть через резистентність до антибіотиків (AMR), що є значним зростанням у порівнянні з 1,14 мільйона у 2021 році. Загалом AMR стане фактором, що впливатиме на 8,2 мільйона смертей щороку.
Дослідження, опубліковане в журналі Lancet і проведене проектом Global Research on Antimicrobial Resistance (Gram) Project, стало першим глобальним аналізом тенденцій антибіотикорезистетності за певний період. Дослідники зібрали дані з 204 країн і територій, щоб оцінити смертність від 1990 до 2021 року та передбачити її до 2050 року.
Ключові спостереження та висновки дослідження щодо смертності від антибіотикорезистентності
- Зниження смертності серед дітей до 5 років:
- У період з 1990 по 2021 рік смертність від AMR серед дітей молодше 5 років зменшилася більш ніж на 50%.
- Незважаючи на загальне покращення, AMR відіграє дедалі важливішу роль у випадках смерті від сепсису серед дітей цієї вікової групи.
- Зростання смертності серед дорослих:
- У той час як смертність серед дітей знижується, у дорослих спостерігається збільшення смертей, спричинених резистентністю до антибіотиків, у різних країнах протягом того ж періоду.
- Прогноз на майбутнє:
- Очікується подальше зниження смертності від AMR серед дітей до 5 років.
- Проте це покращення буде супроводжуватися зростанням смертності в інших вікових групах, особливо серед літніх людей.
Метицилін-резистентний Staphylococcus aureus (MRSA) став лідером серед причин смертей, пов’язаних з антибіотикорезистентністю, значно збільшивши кількість випадків: від 261 000 пов’язаних смертей у 1990 році до 550 000 у 2021 році. Особливо небезпечними стали грамнегативні бактерії, стійкі до карбапенемів. Кількість смертей через ці бактерії зросла з 619 000 у 1990 році до понад 1 мільйона у 2021 році.
Дослідження також показало, що мільйонам смертей можна запобігти завдяки кращій профілактиці інфекцій, покращенню доступу до медичної допомоги та розробці нових антибіотиків. Водночас, смертність серед людей віком понад 70 років вже зросла на 80% за останні 30 років, а до 2050 року очікується зростання на 146%.
Глобальні лідери зустрінуться цього місяця в Нью-Йорку на Генеральній асамблеї ООН, щоб обговорити загрозу антимікробної резистентності. Очікується ухвалення політичної декларації з метою скоротити смертність від супербактерій на 10% до 2030 року.